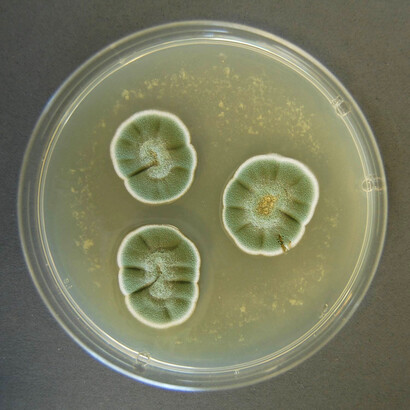
Cultivo de hongo Penicillium, género de hongos más abundante en suelos
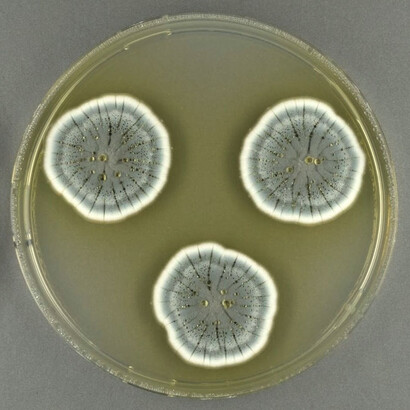
Muchas especies de Penicillium son beneficiosas para los seres humanos
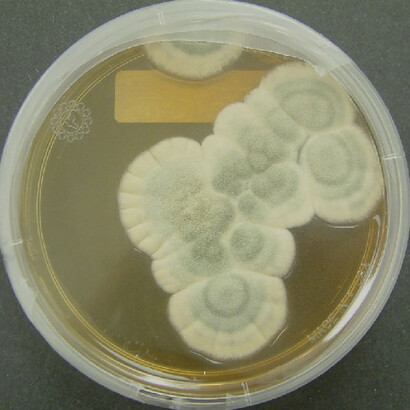
El antibiótico penicilina es producido por el hongo «Penicillium chrysogenum», un moho ambiental

El médico, como era su costumbre, colgó ceremoniosamente su bata blanca del gancho adosado a la pared. Se dirigió a la oficina en donde estaba sentada su secretaria y con inconfundible acento escocés, que no había perdido pese a que llevaba más de tres décadas viviendo en Londres, se despidió cortésmente de ella, por ausentarse de vacaciones por unos días. También lo hizo con su jefe, el eminente Dr. Almorth Wright, reconocido por su titánico esfuerzo en conseguir una vacuna contra la tifoidea, quien revisaba en ese instante en la misma oficina, una correspondencia que le había llegado. Ambas personas respondieron su saludo, deseándole un merecido descanso y un disfrute pleno con sus familiares.
Quince días después, estaba de vuelta en su trabajo, cargado de entusiasmo y energía, deseoso de reanudar sus experimentos, especialmente con el virus de la gripe. Su laboratorio en el hospital Saint Mary era modesto y no tenía mucho personal que lo ayudara en su faenar. Después de los saludos protocolares a sus compañeros, comenzó a ordenar sus utensilios de trabajo, que habían quedado como los dejó. Su vista se posó al rato en unos platos de Petri que había dejado sembrados con unas cepas de * Staphylococcus aureus * y algo inusual llamó su atención. Una capa de moho había crecido accidentalmente en la siembra, formando un círculo libre de bacterias alrededor de la misma. Tal hecho le llamó la atención y en vez de proceder a eliminar la siembra, se puso a tratar de buscarle una explicación a lo sucedido. Era evidente que el moho había destruido a las bacterias, por consiguiente, debía poseer una sustancia capaz de ese poder bactericida. Para ese médico, tal detalle no era nuevo. Seis años atrás, en 1922, había descubierto la lisozima, que tenía una parecida capacidad de disolver agentes patógenos.
El siguiente paso consistió en reproducir lo observado. Con cierto asombro, vio cómo, en efecto, el contacto del moho con los Staphylococcus aureus, causaba la lisis de estos. A continuación, procedió entonces identificar al hongo y así lo hizo, descubriendo que se trataba del Penicillinum nonatum. De allí, entonces dedujo que la sustancia inhibidora del crecimiento de las bacterias debía llamarse penicilina. Luego, intentó su aislamiento, pero por más que lo intentó, no lo logró. Pensó al principio que era una enzima, sin suponer en ese momento, que había descubierto uno de los primeros antibióticos, que cambiarían en mucho la práctica de la medicina. Pudo demostrar a continuación su poder terapéutico en personas, como antiséptico tópico, así como en solución inyectable, pero se requería un equipo multidisciplinario para seguir adelante.
Continuó por un tiempo tratando de estabilizar y aislar la penicilina, pero contando con apenas dos jóvenes investigadores como ayudantes, llegó a la conclusión de que seguir intentándolo era inútil. Su descubrimiento apenas había captado la atención de unos pocos para ese entonces y no había ninguna manifestación de invertir recursos económicos por los sectores de la industria o de la esfera oficial. Alexander Fleming, que así se llamaba este agudo investigador, decidió que era mejor continuar abriendo camino por otros senderos y se olvidó por el momento de la penicilina.
Sus primeros pasos
Nació en Lochfield, muy cerca de Darvel, en la zona de Ayrshire, Escocia, el 6 de agosto de 1881, hijo de una familia de agricultores y criadores de animales, constituida por Hugh Fleming y Grace Stirling Mortonen. Fue el tercero de los cuatro segundos hijos de Hugh, ya que con su primera esposa tuvo los primero cuatro. Es decir, Alexander era el séptimo hijo. Teñía trece años cuando su padre falleció de avanzada edad.
Sus primeros estudios los realizó en las escuelas de Louden Moor, de Darvel y en su ciudad natal. Esos primeros años en un ambiente duro campestre en el sureste de Escocia, lo hicieron ser un niño muy observador y apreciador de la naturaleza. Después de la muerte de su padre, a los catorce años se dirige a Londres para vivir con su hermano mayor de nombre Thomás, que era médico oculista, con el fin de terminar sus estudios básicos en el Regent Street Polytechnic. A continuación, para obtener recursos económicos propios, busca empleo como asistente administrativo en una compañía naviera de Londres y allí permanece por espacio de cuatro años.
Como su meta era estudiar medicina, cuando recibe una pequeña herencia dejada por su tío y logra una beca, se inscribe en la escuela de medicina de Santa María, adscrita a la universidad de Londres, a la edad de veinte años. En esa etapa, se distingue como un estudiante de primera clase, tanto que, al graduarse, obtiene la medalla de oro como el mejor estudiante de la carrera. También se distingue en los deportes, especialmente figura en los equipos de natación, de polo acuático y de tiro al blanco. Además, demostró tener bastante habilidad para la pintura (Greene, J. E.). Primariamente, se siente tentado a seguir la carrera de cirujano, pero una pasantía que realiza en el laboratorio de su escuela de medicina, le hace interesarse por el campo de la bacteriología. Así lo hace y prontamente, recibe la influencia de Sir Almroth Wright, toda una autoridad en dicha especialidad y también en el de la inmunología (Britannica). A instancias de Wright es nombrado lecturer de la escuela de Santa María, en donde permanece hasta 1914, ya que, al estallar la Primera Guerra Mundial, se inscribe en el ejército en donde sirve durante todo el conflicto hasta su finalización, alcanzando el grado de capitán del Cuerpo Médico del Ejecito. Se debe señalar que, en 1900, cuando solamente tenía 19 años, se alistó en el London Scottish Regiment para participar en la guerra de los Boers, pero antes de entrar en acción, esta terminó, finalizando así su aventura militar. Sin embargo, continuó como agregado voluntario a su sección, hasta su intervención durante la Primera Guerra Mundial.
Es preciso decir también que, entre el año 1909 y principios del 1914, abrió un consultorio de práctica médica privada para pacientes con enfermedades venéreas, que fue muy exitoso, seguramente apoyado en su gran práctica bacteriológica. Fue uno de los primeros médicos de Gran Bretaña que aplicó el neosalvarsán contra la sífilis, descubierto por Erchlich años atrás en Alemania. El conflicto del año 14 impidió que continuara ejerciendo como médico privado.
Como capitán médico del ejército británico, trabajó como bacteriólogo al lado de su gran amigo de toda la vida, Almorth Wright, que había instalado un laboratorio en Boulogne, Francia. Allí estudió las infecciones por heridas de guerra, demostrando la ineficacia del tratamiento fuerte con antisépticos, recomendando que bastaba con una limpieza a fondo, para mantener limpias las heridas, utilizando, además, una solución salina suave. En esa etapa ayudó a Wright a proporcionar su vacuna contra la fiebre tifoidea, que sin duda salvó a muchos soldados de tener dicha enfermedad o de morir a causa de ella. Terminada la guerra, Fleming regresó a la escuela de Santa María para continuar su labor docente e investigativa.
Sus años de gloria
La experiencia de la guerra al ver tantas infecciones que ocasionaban la muerte de los soldados heridos renovó su interés en investigar los mecanismos o medios para evitar o detener el contagio. Siguió con sus experimentos sin éxito, hasta que, en 1922, cuando estaba sufriendo un fuerte catarro común, observando las muestras cultivadas de su secreción nasal, observó que cuando les añadía un poco más de ese moco diluido, los elementos microbianos desaparecían. Entusiasmado por su hallazgo, empleó otras secreciones humanas como lágrimas, saliva, etc., encontrando iguales resultados. Comprendió que en dichas sustancias naturales había elementos que parecían inhibir o destruir algunos agentes infecciosos y también percibió su importancia práctica. Denominó lisozima a ese agente poderoso que podía contribuir a combatir las enfermedades infecciosas, sin alterar las células y tejidos sanos, comunicando de inmediato su hallazgo a la Real Sociedad de Londres. Intentó aislar esta enzima para tratar un número grande de pacientes, pero dadas las limitaciones de su laboratorio, no pudo hacerlo, por lo que el éxito fue limitado (Greene, J. E.). Sin embargo, representaba un gran aliciente para Fleming, que había seguido desde un principio, la línea de investigación de Erhlich de encontrar sustancias naturales que, sin dañar al organismo, tuvieran efectos bactericidas (Fernández, T. y Tamara, E.).
Fleming siempre consideró que su investigación sobre la lisozima «había sido su mejor trabajo como científico, dado su aporte a la mejor comprensión de cómo el organismo contribuye de manera significativa para combatir las infecciones». Lamentablemente, como se dijo, esta enzima no tuvo efecto sobre la mayoría de las bacterias (Britannica).
El verdadero éxito de Fleming y que le dio una eterna gloria fue el descubrimiento de la penicilina. Ya escribimos en la introducción, algunas facetas de cómo se realizó dicho hallazgo. Tenía que estallar la Segunda Guerra Mundial, en septiembre de 1939, para que el interés por la penicilina resucitara. Un equipo de la Universidad de Oxford, liderado por Howard Florey, quién había nacido en Adelaida, Australia, el 24 de septiembre de 1898, se encargó de esas nuevas investigaciones. Estudió medicina en su ciudad natal y en Oxford. En esta última universidad fue profesor de patología entre 1935 y 1962. Estudió la inflamación tisular y las secreciones de las membranas. Tuvo éxito al purificar la lisozima. En 1939 se dedicó casi por completo al estudio de la penicilina, logrando con su compañero de equipo, el Dr. Ernst Boris Chain, así como con otros investigadores, realizar pruebas en humanos mediante ensayos clínicos de la eficacia de la penicilina. Igualmente, lograron crear un método para su producción masiva. Chain había nacido en Berlín, Alemania, el 19 de junio de 1904 y emigrado a la Gran Bretaña a principios de los años treinta, escapando de la persecución desatada por Hitler contra los judíos. De profesión bioquímico, desde 1935 entró a la Universidad de Oxford, para trabajar con Florey.
Luego, el equipo se trasladó a Estados Unidos logrando la producción en masa del antibiótico que pudo, así, ser utilizado en la Segunda Guerra Mundial, salvando la vida de millares de soldados que tenían heridas infectadas. En 1945, Alexander Fleming, Howard Florey y Ernst Boris Chain recibieron conjuntamente el premio Nobel de medicina, por sus grandes aportes al descubrimiento y producción de la penicilina.
Los años finales
Al fin, Fleming vio recompensada su vida de esfuerzo y lucha en el campo de la investigación. En 1944 le fue otorgado el título de Sir. Además, obtuvo reconocimientos de todo el mundo. Las universidades de Londres, Toronto, Filadelfia, Edimburgo, Harvard, entre otras le nombraron profesor asociado, Obtuvo la medalla al mérito de los Estados Unidos y la gran cruz de Alfonso el sabio de España, siendo además nombrado canciller de la universidad de Camberra, Australia.
Fue declarado presidente de la sociedad de microbiología general, así como miembro de la academia pontificial de ciencia. Además, fue nombrado miembro honorario de casi todas las sociedades médicas y científicas del mundo. Entre 1951-54 fue rector de la universidad de Edimburgo y recibió el título de Doctor Honoris de treinta universidades europeas y norteamericanas.
Escribió numerosos trabajos científicos sobre bacteriología, inmunología y quimioterapia, que fueron publicados en las más importantes revistas del mundo. Dictó conferencias en numerosas universidades y sitios públicos, por lo que en realidad de los tres que recibieron el Nobel, fue el más reconocido, quizás también por el excelente trato que tuvo con los periodistas y su fácil comunicación con el público. De ser al principio un hombre reservado y hasta tímido, de difícil expresividad como conferencista, la fama lo cambió totalmente, ya que lo deslastró de su inseguridad y falta de confianza en sí mismo, transformándolo en una personalidad extrovertida, que disfrutaba de los actos públicos y con muy buena capacidad oratoria. Los reflectores públicos lo convirtieron en un verdadero «embajador mundial de la medicina y la ciencia». De repente, se convirtió en uno de los científicos más conocidos a nivel global.
Tanto Florey como Chain, también recibieron numerosos reconocimientos mundiales. Entre otras muchas premiaciones que recibieron, al igual que Fleming, ellos dos fueron nombrados «caballeros» del reino.
Aspectos personales
In 1915, Fleming se casó con la enfermera Sarah Marion McElroy, nacida en Kilalla, Irlanda, quién falleció en 1949. Con ella tuvo un hijo único, nacido en 1924, de nombre Robert, que también se graduó de médico y ejerció su profesión como generalista. Cuatro años después de viudo, se casó por segunda vez en 1953 con una colega de origen griego, la Dra. Amalia Koutsouri Voureka, quien trabajaba en el hospital de Santa María y a quien había conocido allí desde 1946, al llegar al hospital como becaria, después de haber participado como «partisana» de las guerrillas griegas en la Segunda Guerra Mundial. Lamentablemente la felicidad de Fleming en ese tiempo le duró poco ya que apenas a los dos años de casado, sufrió un infarto agudo al miocardio, que le ocasionó la muerte el 3 de noviembre de 1955. Fue enterrado en la catedral de San Pablo en Londres.
Notas
Britannica. Alexander. Fleming. A Scottish bacteriologist. Kevin Brown, editor.
Fernández, T. y Tamaro, E. (2004). Alexander Fleming. Biografía. Biografías y Vidas. La enciclopedia biográfica en línea. Barcelona, España, 2004.
Greene, J. E. (1978). 100 grandes científicos. Editorial Diana.
NobelPrize.org. Sir Alexander Fleming – Biographical.